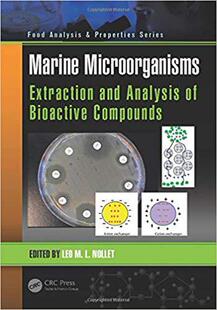

Microorganisms Foods Testing Microbiological 预售
¥2550满1999减300售0件

预订 Microorganisms Genetics Halophilic 9783039289554
¥936满500减110售0件
Microorganisms Marine 预售
¥2577满1999减300售0件

and Microorganisms Fermentation Foods Traditional 预售
¥2577满1999减300售0件

Sustainable 9789390175031 Important And Applications Mechanisms Agriculturally Microorganisms Agriculture For 预订
¥2579满1999减300售0件

Analysis Indoor 预订 室内微生物污染高级手册 and Microorganisms 9780471730934 Sampling
¥1555满999减180售0件

Unveiling Analysi Bioinformatics through Microbe Hunting Assessment Secrets the and 预订 Sequencing Microorganisms
¥1560满999减180售0件

Pathogenic 9781014135278 for Some Habitat Soil Microorganisms Plant 预订
¥262满200减30售0件

Identification Carbon Microorganisms for Sensors Impedimetric based Point Modern 预订
¥262满200减30售0件

Applications Biotechnological Extremophilic 9783110427738 Microorganisms 预订
¥1580满999减180售0件

Microorganisms 9783110524642 Advanced Environments Extreme Studying for Techniques 预订
¥1580满999减180售0件

Sustainable the 预售 Environment and Microorganisms Food Agriculture
¥1582满999减180售0件

Mechanisms Biocontrol Endophytic 9780323884785 Microorganisms 预订
¥1600满999减180售0件

for Microorganisms Sustainable Environment Health and 预订
¥1600满999减180售0件

Home and Work Microorganisms Indoor Environments 预售
¥2712满1999减300售0件

预订 Microorganisms Metabolic 9781021493484 Pathways
¥273满200减30售0件

Microorganisms Must 预售 and Biology Grapes
¥2738满1999减300售0件

Strategies Survival Cold Microorganisms adapted 预订
¥2738满1999减300售0件

Strategies Cold Microorganisms Survival adapted 9789811626241 预订
¥2738满1999减300售0件

预售 Multicellular Beneficial Life Microorganisms
¥1643满999减180售0件

Microorganisms Halophilic 预售
¥1643满999减180售0件

Soil based Agriculture Halotolerant Saline Microorganisms 预订
¥1643满999减180售0件

Solubilizing Potassium Microorganisms for Agriculture Sustainable 预订
¥1643满999减180售0件

Proteolysis Regulated Microorganisms 预订
¥1643满999减180售0件

Microorganisms Beneficial Multice... 预订
¥1643满999减180售0件

Microorganisms Halophilic 预售
¥1643满999减180售0件

Microorganisms Beneficial Food Nutraceuticals and 预售
¥1643满999减180售0件

Microorganisms Plant Conservation Biodiversity and 预订
¥1643满999减180售0件

预订 for Engineering Microorganisms th...
¥1643满999减180售0件

Soil based Agriculture Halotolerant Saline Microorganisms 预售
¥1643满999减180售0件